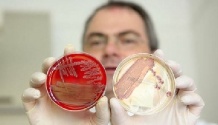
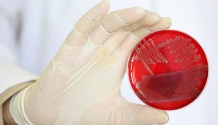

BFL
Tyrėjai, ieškantys Europą apėmusio sunkių bakterijų žarnyno infekcijų protrūkio šaltinio, aiškinasi, iš kur gaudavo produktus vienas restoranas Vokietijos šiaurėje, kuriame apsilankę susirgo 17 žmonių, sekmadienį pranešė vietos žiniasklaida.
Baltijos pajūrio mieste Liubeke veikiančio restorano “Kartoffelkeller” savininkas Joachimas Bergeris sakė visuomeninei televizijai ZDF, kad sveikatos apsaugos inspektoriai paėmė mėginių jo maitinimo įstaigoje po to, kai susirgo trys atskiros grupės restorane valgiusių žmonių.
Per pastarąjį mėnesį pavojingos atmainos bakterijomis Escherichia coli užsikrėtė ir susirgo daugiau nei 2 tūkst. žmonių, daugiausiai šiaurės Vokietijoje.
Mažiausiai 19 pacientų mirė, išsivysčius hemoraginiam enteritui, pasireiškiančiam pilvo skausmais, kraujingu viduriavimu, karščiavimu ir vėmimu.
Pasak J.Bergerio, sveikatos apsaugos pareigūnai nurodė, jog tarp 17 susirgusių žmonių buvo vienos šeimos nariai, grupė turistų iš Danijos ir grupė mokesčių pareigūnių. Visi šie asmenys valgė J.Bergerio restorane gegužės 13 dieną ir užsikrėtė hemoraginį enteritą sukeliančiomis E.coli (EHEC).
Tikėtina, kad restorano svečiai, kurie pasijuto blogai, valgė kepsnį ir salotas.
Dienraščio “Bild” sekmadieninis priedas rašo, kad viena 48 metų mokesčių inspektorė vėliau mirė. Kitos aštuonios tebeserga, o dviejų moterų būklė kritinė.
“Ar neturiu ko slėpti – esu tikras, kad restorane viskas tvarkinga”, – laikraščiui sakė 67 metų J.Bergeris.
Inspektoriai atidžiai ištyrė restorano virtuvę ir paėmė visų jo darbuotojų išmatų mėginius, nurodė savininkas. Jis pridūrė, kad nesusirgo nei vienas iš darbuotojų, kurie valgė tą patį maistą kaip restorano svečiai.
Regioninės vartotojų teisių ministerijos atstovas Kristianas Zeifertas sakė naujienų agentūrai AFP, jog prielaidos apie “Kartoffelkeller” ryšį su pastaruoju protrūkiu nepagrįstos.
J.Bergeris nurodė, jog maisto produktus restoranui tiekia didmeninės prekybos tinklas “Moelln”, kuris savo ruožtu juos perka iš centrinio maisto produktų turgaus šiauriniame Hamburgo uostamiestyje. Šiame mieste taip pat buvo užfiksuota daug užsikrėtimo EHEC atvejų.
Vokietijos sveikatos apsaugos ministras Danielis Baras, sekmadienį planuoja aplankyti Hamburge esančią Ependorfo universiteto kliniką, kurioje gydoma daug EHEC užsikrėtusių pacientų, Jis perspėjo, kad infekcijų židinys tikriausiai tebėra aktyvus.
“Maisto higienos pareigūnai dirba apskritą parą, mėgindami nustatyti infekcijų šaltinį, – D.Bahras šeštadienį sakė dienraščiui “Ruhr Nachrichten”. – Tačiau iš ankstesnių protrūkių žinome, jog ne visada pavyksta nustatyti šaltinį.”
“Negalima atmesti, kad infekcijų šaltinis tebėra aktyvus”, – pridūrė jis, pabrėždamas, jog vartotojai privalo išlikti budrūs, o pareigūnai vis dar pataria nevalgyti šviežių pomidorų, salotų ir agurkų.
Duodamas interviu “Bild am Sonntag” D.Bahras pažymėjo, jog kai kuriose šiaurės Vokietijos ligoninėse, ypač Hamburge ir Brėmene, padėtis tebėra “sudėtinga” dėl didelio naujų pacientų srauto. Ministras sakė, kad pagalbos kreiptasi į kitas ligonines.
Hamburgo vyriausioji sveikatos apsaugos pareigūnė senatorė Kornelija Priufer-Štorks sakė transliuotojui NDR, kad užsikrėtimų EHEC atvejų veikiausiai jau mažėja.
Pasak jos, Hamburge nuo penktadienio iki šeštadienio užregistruota 19 patvirtintų arba įtariamų EHEC infekcijos atvejų, taip pat vienas naujas sunkus hemoraginio enterito (HUS), kuris gali pažeisti inkstus, atvejis.
Pasaulinės sveikatos organizacijos duomenimis, HUS susirgo mažiausiai 552 žmonės.
Anksčiau skelbti Hamburge užsikrėtusių žmonių skaičiai buvo daug didesni.
Apie užsikrėtimų pavojingos atmainos E.coli atvejus taip pat pranešė 12 kitų šalių, tarp jų Austrija, Didžioji Britanija, Čekija, Danija, Prancūzija, Nyderlandai, Norvegija, Ispanija, Švedija, Šveicarija ir JAV. Nurodoma, kad visi šie pacientai neseniai lankėsi Vokietijoje.
Dauguma susirgusių buvo moterys, todėl tikėtina, kad užkrato šaltinis “tikriausiai yra kažkas, ką moterys mėgsta labiau negu vyrai”, – nurodė Pasaulinės sveikatos organizacijos maisto saugumo skyriaus epidemiologė Andrėja Elis.